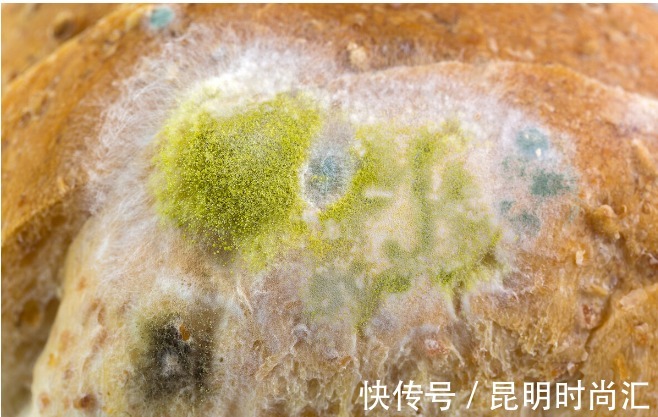
毒素|黄曲霉毒素很狡猾,如果你家里厨房有这5种情况,抓紧收拾

最近关于黄曲霉毒素的话题很热,主要原因是它的致癌性,尤其是在我们的生活中很容易遇到,很难预防。尤其是厨房,上次我们讲了厨房里最容易出现黄曲霉毒素的五个地方,容易被忽视,平时要多加注意。所以我们今天想说的是,如果这五种情况发生在厨房,一定要及时清理,否则影响很大,患癌症的风险也会增加。为什么这么说?这是因为黄曲霉毒素是以孢子的形式传播的。什么意思?也就是说,如果黄曲霉毒素出现在菜板或筷子上,没有及时清理干净,那么这些黄曲霉毒素就不会老老实实地留在菜板或筷子上,而是会离开父母,即从筷子或筷子上出去,然后降落在其他地方,直接或间接地发育成新的个体生殖细胞,进而产生更多的黄曲霉毒素细菌。所以一旦发现黄曲霉毒素,所有厨房都要清理干净,而不是只清理一个。那么厨房里最容易被忽视的五种情况是什么呢?
1.如果一包花生只有一颗碎了,那么这包花生就应该扔掉,不能再吃了,因为黄曲霉毒素的孢子已经遍布了其他花生,但它们还没有时间继续繁殖。2.如果在存放食物的柜子里发现了霉变和黄曲霉毒素,放在露天地方的食物需要清洗,不能再吃了。此外,存放食物的柜子应该打扫干净。所以养成封菜的习惯。3.食物残渣留在角落里,要及时清理,不用麻烦,以后也不要想着清理,因为很容易忘记这些残渣时间长了会发霉产生黄曲霉毒素。建议回家看看有没有哪个角落有这样的情况。
4.劣质芝麻糊。为了节约成本,一些商家会用质量差甚至不变的花生、芝麻来制作芝麻酱。价格比较低,但是黄曲霉毒素可能存在。所以,看看家里的芝麻酱是不是正规超市买的正规品牌,有没有什么没有商标的品牌是家里带回来的,因为现在的世界是纯天然的,他们种出来的东西是好的,但是往往更容易上当受骗,出问题。5.在非正式的车间里自己提炼石油。其实有很多自己榨油的小作坊,都是用自己的非转基因大豆。榨出的油比外面好,但问题在于这个车间榨油工艺简单,没有去除有害物质的工艺,原料无法提炼,重金属污染的风险,高致癌物黄曲霉毒素的存在。
黄曲霉毒素可以说是我们生活中难以预防的致癌物。因此,我们应该做好厨房的清洁工作,切断所有可能的黄曲霉毒素来源,防止更多其他细菌的滋生,减少对健康的危害。也是一个提醒,买的时候不要买太多的食物,购买后密封保存,避免浪费食物
推荐阅读
- 溶解度|“洗衣粉”和“洗衣液”究竟哪个好?不看不知道,“差距”很大
- 水地暖|为什么很多人不想装地暖内行人总结了6大缺点,住过的人都懂
- 水箱|家里水费翻倍交?只需一根绳子,每月很简单能省下一半水费,厉害
- 泥工|包下水管师傅要收双倍费用,起初不了解,后来发现真的很值
- 地板|为何别人家很干净,自己家却容易乱?经验之谈:没有这7个习惯
- 废纸|不用卫生间时,门开着好还是关着好?很多人做错,难怪家里有异味
- 厕纸|家里的这3样东西,最好“淘汰”了!很多人不了解,还在往家里搬
- 沐宸|30岁姑娘把家装得清爽淡雅,氛围很温馨,邻居纷纷称赞:住着舒服
- 阿姨|52岁阿姨的新居,全屋装修“一尘不染”的奢华,让人觉得很是羡慕
- 吊顶|78平米小户型,面积不大,却很舒适温馨,满满的烟火气息














